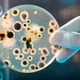
Celulas

-
Filósofo Griego
Fundación del atomismo -
Demócrito, discípulo de Leucipo
-
Aristóteles defendía la continuidad de la materia, que no hay espacios vacios
-
Hans Lippershey diseño el primer telescopio práctico y es considerado como el inventor del microscopio
-
Hans Janssen y Zacharias Janssen
Aumento de 9 veces la visión del lente del microscopio -
Galileo Galilei reinventa el microscopio
-
Francesco Stelluti publica primeros relatos de observaciones al microscopio
-
Robert Hooke publica su libro con los primeros dibujos observados con microscopios
-
Marcello Malpighi descubrió estomas y capilares
-
René Joachim Henri de Dutrochet
Primero en reconocer la importancia del pigmento verde en el uso de CO2; descubrió el fenómeno de ósmosis -
Robert Brown médico y botánico escocés
-
Hugo van Mohl
Es la fuente de todos los movimientos y describe su comportamiento durante la división celular -
Matthias Jakob Schleiden
"los vegetales son agregados de seres completamente individualizados, independientes y distintos" -
Rudolph Virchow propone a la célula como la unidad orgánica
-
Charles Ernest Overton es el pionero en la teoria de la membrana celular
-
Max Knoll y su alumno Ernest Ruska
A list shows items. A timeline shows sequence.
Use Timetoast to make dates, milestones, and turning points easier to understand in a clear visual format. Timetoast is a timeline maker for work, school, research, and stories.